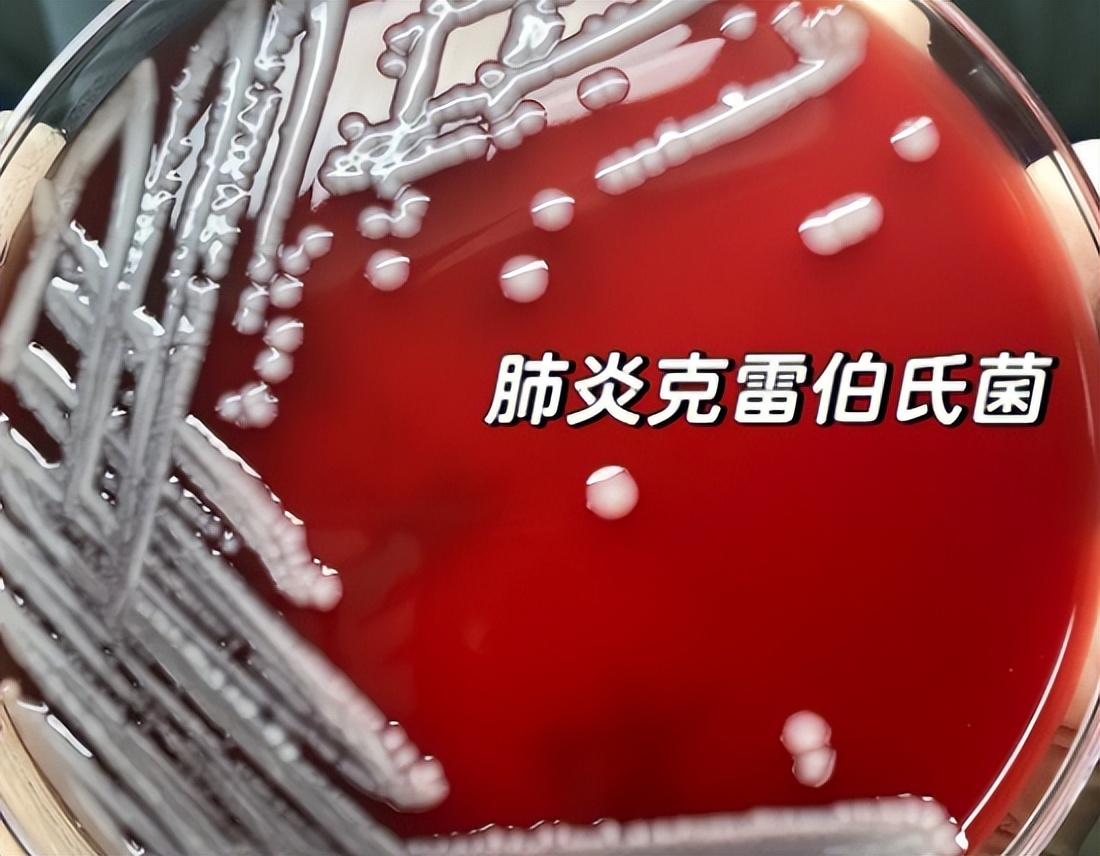
医院内尿路感染常见的诱因,尿路感染最严重的后果

导管相关性尿路感染(CRUTI)占到医院植入物相关感染的70%以上,是最常见的感染之一。研究报道有大达16%的患者在住院期间有留置导尿管史。
在我国,尿路感染占到院内感染的20.8%-31.7%,仅次于呼吸道感染。尿路感染也是导致病死率升高的第三大原因,同时增加了患者的经济负担与医疗成本。

而尿路感染的病原菌则主要通过直肠及阴道的定植菌异位感染所致,这与器械、集尿袋和尿管-引流管连接处的污染密不可分。本文通过对国内外目前对于CRUTI的相关研究的介绍,旨在为CRUTI的深入研究提供启示,为CRUTI的预防与治疗提供参考。
一、CRUTI的致病机制
CRUTI 主要是由于导尿管的存在和长期留置导致的。导尿管插入膀胱的机械力导致了尿道的炎性反应和膀胱黏膜水肿,逆行插入的导尿管导致尿道口定植的大肠杆菌的上行感染,并且为其提供了附着面积,更容易发生感染。

大肠杆菌根据生物种系发生型分为八种:为A型、B1型、B2型、C 型、D型、E型、F型和I型。在J.H.Lee等人的研究中,导致尿路感染的大肠埃希菌 79.31%属于B2型,15.51%属于D型,这与之前大多数研究得出的结论相似。
Masoud Rahdar的研究指出fim,pap和sfa操纵子与尿路感染的发生密切相关。pap 与 afa操纵子的共同出现率高达 50%以上,而 sfa 操纵子的阳性率则高达 80%,这些数据提示这些基因与尿路感染发生的密切联系。

而 J.H.Lee 的研究也表达相同的观点,sfa 操纵子与 fimH 基因的阳性率都高达了 100%,papA 也有 39.6%的阳性率,提示了 sfa 与 pap 在细菌与宿主肾组织细胞的粘附上都起到了主要的作用。
对于UPEC的毒力因子都进行了深入的研究,提示我们B2 型和D型种系发生型以及fim,sfa,pap,afa等毒力基因与尿路感染的发生有着密切的联系,对于尿路感染的治疗可以通过对于这些毒力因子基因功能的了解进行更加深入的研究。

在尿路感染的基础之上,增加导尿管的使用则会使得尿路感染的几率增大。因为导尿管接触尿液后,尿液中存在的少量细菌的黏附素将会黏附到导尿管表面,然后分泌大量的细胞外聚多糖,促进微生物聚集形成成熟的生物膜。
据国外相关研究,生物膜的形成可以提高其中病原微生物的耐药性,使得相关抗生素的作用大大降低,并且生物膜中的化学物质能诱导病原微生物的耐药基因,促使耐药菌的增多。

肠球菌则是生物膜中分离出的最多菌种,高达 87.5%。需要指出的是,该研究报道生物膜与性别、导管留置时间和导管材质之间存在有统计学意义的联系,男性,长时间导管留置时间以及乳胶管更容易有生物膜的产生。
二、CRUTI的病原菌分布
在王艳艳等人的研究中,CRUTI 的病原菌分布中革兰阴性杆菌占到 79.09%,其中大肠杆菌占首位,其后分别为肺炎克雷伯菌、鲍曼不动杆菌、铜绿假单胞菌、阴沟肠杆菌、奇异变形杆菌、弗劳地柠檬酸杆菌。

大肠杆菌仍然是感染的主要病原菌,这与目前大多数文献的报道相符。而在马弘文等人的研究中,大肠杆菌也占了首位(41.18%),排在其后的依次是真菌、克雷伯杆菌属、阴沟肠杆菌、变形杆菌。
综上所述,在目前 CRUTI 的病原菌分布主要以革兰阴性杆菌依旧为主,大肠杆菌仍然是最多的病原菌类型,其他的有肺炎克雷伯菌、铜绿假单胞菌、鲍曼不动杆菌以及奇异变形杆菌等。

其次为革兰阳性球菌,主要是肠球菌属,其中屎肠球菌普遍比粪肠球菌多。真菌所占比例与革兰阳性球菌相似,不同地区和医院的统计数据可能会存部分差异。
三、CRUTI的病原菌耐药性
研究数据显示CRUTI中的大肠杆菌对碳青霉烯类的耐药率为0.7%-1.2%,肺炎克雷伯菌属的耐药率为3.1%~12.5%。大肠杆菌对头孢类、青霉素类和磺胺类药物的耐药率都较高,而肺炎克雷伯菌对所有抗菌药物的敏感率均超过40%。
在非发酵菌中,也有半数以上对头孢他啶耐药。60%的肠球菌对氨苄西林耐药,而对万古霉素更加敏感,耐药率较低。而金黄色葡萄球菌中,有一半以上对甲氧西林耐药。
因此,由于产超广谱β内酰胺酶的大肠埃希菌和肺炎克雷伯菌有将近一半左右,所以对于细菌的用药,头孢菌素和青霉素类的耐药情况比较严重,另外喹诺酮类的耐药性形势也比较严峻,相对而言,酶*制剂抑**更敏感。

而非发酵菌中,也大多数对三代头孢菌素耐药率较高,碳青霉烯类耐药率在 25%左右,鲍曼不动杆菌对米诺环素较为敏感,而铜绿假单胞菌对阿米卡星最为敏感。
四、CRUTI的影响因素
1、性别和年龄
有研究报道,CRUTI中女性感染率约是男性三倍左右,这可能是因为女性尿道短而直,并且尿道口与阴道及肛门较近,导致细菌容易污染、入侵,从而产生尿路感染。

在年龄方面,40岁以上患者感染率高于 50%,40 岁以下则仅为 5%,可见年龄越大,感染几率越高,可能与泌尿系统的解剖结构改变和生理功能水平下降有关。
2、留置时间
在刘映兰的研究中,≤2 天的留置导尿时间,感染率为 6.25%,3~7 天的感染率为 26.6%,8~13 天的感染率为 50.9%,而≥14 天的感染率则达到了 100%,这与李春辉的研究几无差异。

而另一篇研究则也显示 3 天内的感染率不足 5%,而 3天以上的感染率则达到50%以上。可见导管留置时间越长,则感染率的几率呈加快增长的趋势,长期导尿管留置则几乎一定会发生感染,导管留置的时间最好控制在三天以内。
3、膀胱冲洗
在涂兰珍的研究中,两种不同的留置导管方式从而进行的膀胱冲洗对之后的尿路感染有显著差异。对于开放式留置导管,需要反复插管,冲洗膀胱,导致感染几率大大增加,而封闭式留置导管则减低了尿道感染的可能性。

而在李友芳的研究中,没有进行膀胱冲洗的患者中,尿路感染的比例为 2.18%,而用生理盐水或碘伏或庆大霉素进行膀胱冲洗的患者都有将近40%的患者尿路感染,与没有冲洗膀胱的患者相比,尿路感染的发生率大大提高,而三种冲洗方式之间没有显著差别。
综上所述,女性及老年人较易感染 CRUTI,对于此类病人应及时做好预防措施。而导管的留置时间应尽量控制在3天以内,最好不要超过7天。应尽量鼓励患者多喝水,以生理性的膀胱冲洗代替人为的膀胱冲洗降低CRUTI感染的发生率。

五、CRUTI的预防措施
1、导管材质
相关研究发现纳米银涂层的导管在长期导管留置患者中的抗菌效果比普通导管好。有研究指出,银涂层导管和呋喃西林导管不但对短期导管留置无效,而且仅能减少无症状菌尿,并不一定能减少CRUTI的发生。
有研究对更加前沿的导管进行了研究,使用阿奇霉素和环丙沙星浸泡过的有机硅导管能有效针对铜绿假单胞菌防止耐药菌的产生。此外,另有研究认为抗菌肽具有高抗菌活性、抗菌谱广、不易产生抗性突变等优点,目前已经有多种抗菌肽用于临床使用的可行性研究。

2、氯已定擦浴
在国内文献报道中,洗必泰(氯已定)的擦浴可以显著降低病人出现 CRUTI,对照组的 CRUTI 发生率是擦浴组的两倍左右。在国外报道中,氯已定擦浴组的CRUTI 发生率显著低于水和肥皂擦浴组,并且念珠菌的分离率也显著降低。
综上所述,在对抗 CRUTI 的预防措施上,应尽量采用封闭式的留置导管,可以采用氯已定擦浴,对有条件的医院及患者可以使用新型导管来降低 CRUTI 的发生率。

六、CRUTI的诊疗方法
1、降钙素原和C反应蛋白
国内相关研究显示 CRUIT 患者的 CRP、PCT 水平明显高于对照组,两者也具一定相关性,并且 WBC 值和体温在两组之间没有差异。而不同细菌感染的 CRP 与PCT 之间并无差异。两者联合使用可以提高灵敏性和特异性,对早期 CRUTI 诊断能提供帮助。
2、药物
目前临床常用的药物,例如环丙沙星、左氧氟沙星、呋喃妥因及复方磺胺甲噁唑等,在耐药性问题上都比较严重,而一些新型药物及疗法也在临床研究中。

最主要的为β-内酰胺类抗生素和β-内酰胺酶*制剂抑**的联合疗法。三代头孢菌素头孢他啶联合β-内酰胺酶*制剂抑**阿维巴坦对产超广谱 β-内酰胺酶和碳青霉烯酶的革兰阴性杆菌有不错的疗效。
另外还有一些正在研究的药物,分别针对细菌附着为靶点,细菌毒素和蛋白酶为靶点,铁载体为靶点为靶点,脲酶为靶点,菌毛为靶点。因此,对于CRUTI的早期诊断不仅可以通过尿培养,也可以通过血清中的降钙素原和C反应蛋白来提高敏感性和特异性。

七、总结
CRUTI 目前是我国院内感染的第二大感染,不仅在泌尿科的患者需要用到留置导管,很多 ICU 的患者也需要留置导管,所以 CRUTI 造成了许多患者的医疗费用增高,留院时间延长。
医院医疗成本提高等诸多问题,解决 CRUTI 的发生率和病程时间将有效减少 CRUTI 所带来的不必要的损失。